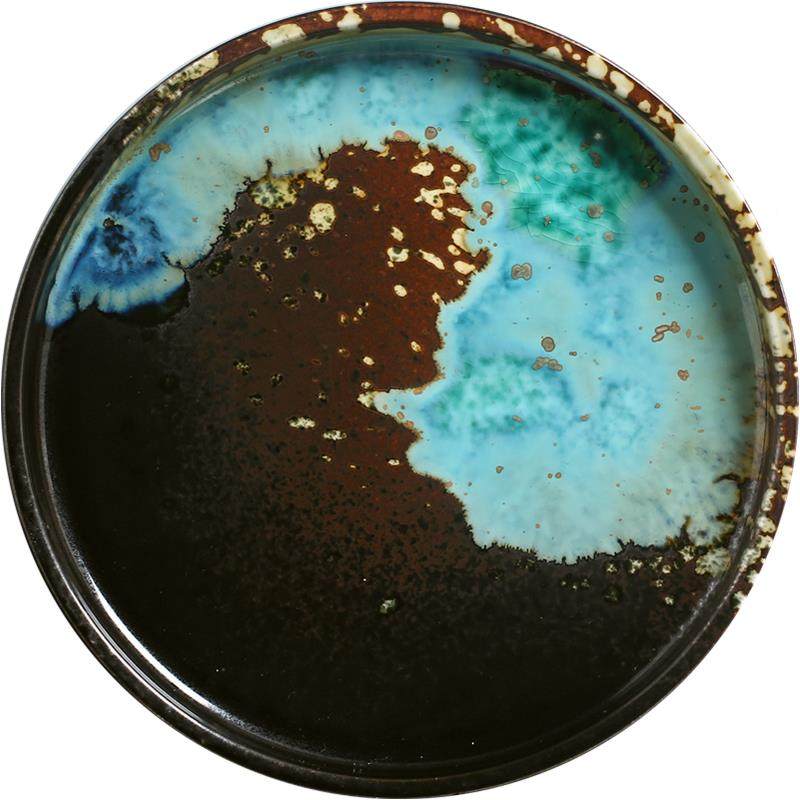
东荣式III陶瓷欧平盘浅盘牛创意形排盘西餐意圆面盘家用水果沙拉

东荣陶瓷品牌简介
东荣陶瓷
景德镇东荣瓷业有限公司是一家集研发、生产、销售于一体,专业生产酒店陶瓷、家居陶瓷的生产企业。享有知名注册品牌“东荣陶瓷”。本厂拥有三万多平方米的生产基地,有先进的生产设备和研发能力。东荣瓷业秉承景德镇千年陶瓷文化,结合个性化的设计理念,东荣瓷业更注重产品的实用性、尊重传统工艺的同时,并不墨守成规,不断完善更新。使生产的产品受到广大客户的肯定和青睐,同时本厂可根据来稿文样制作产品,满足客户的一切需求。发展中的东荣瓷业,以独特的眼光、超前的意识、实施品牌策略、树立企业形象。以市场为导向、科技为后盾、人才为根本,东荣瓷业将一如既往,以崭新的面貌昂扬前进,与您携手共创未来。
品牌店铺

东荣陶瓷旗舰店